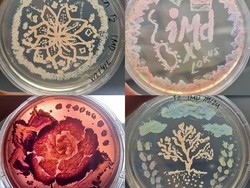
Mahasiswa ITB Bikin Petri-dish Art, Seni Lukis Menakjubkan dari Kumpulan Mikroba

detikSulsel
22 Contoh Teks Hikayat dengan Berbagai Tema Lengkap Ciri-Strukturnya
Teks hikayat berisi cerita kepahlawanan, sejarah, dan mitos. Temukan contoh, ciri, tujuan, dan struktur teks hikayat dalam artikel ini.
Jumat, 11 Okt 2024 23:00 WIB